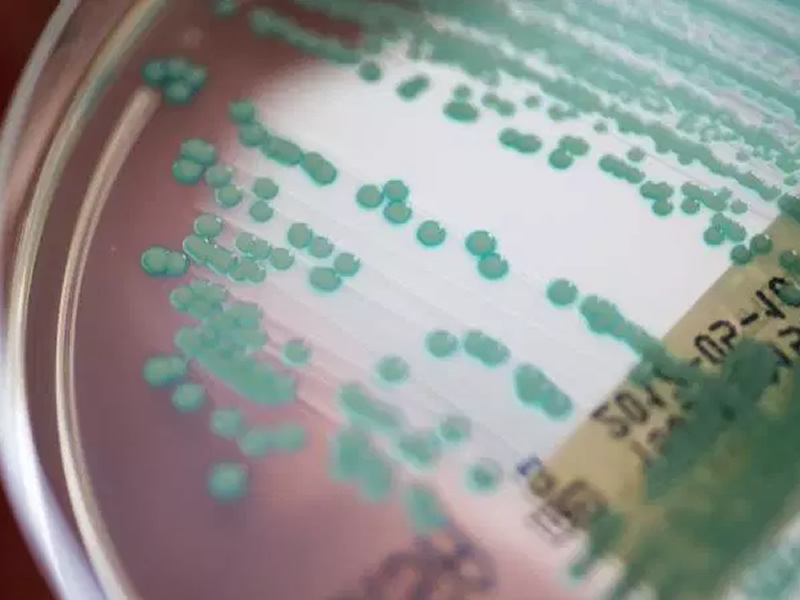
/18303ciencia.jpg

Editoria Ciência

Trânsito de Mercúrio: Brasil verá ´mini eclipse´ do planeta vizinho pela 4ª vez no século
Nesta segunda-feira (11) à tarde, Mercúrio ´passará na frente´ do...

Cientistas planejam criar câncer para pesquisar sinais precoces da doença
Grupo mira desenvolvimento de testes menos invasivos, como os de sangue e u...

Brasileiro com câncer terminal terá alta após terapia genética pioneira obter sucesso pela 1ª vez na América Latina
Homem de 62 anos tinha linfoma e tomava morfina todo dia. Pesquisa da USP-F...

Cientistas encontram água em planeta potencialmente habitável
Estudo afirma que planeta K2 - 18b tem características que podem propiciar ...

15 universidades públicas produzem 60% da ciência brasileira
Relatório da empresa Clarivate Analytics traça cenário da produção científi...

Cientistas criam lente de contato que dá zoom
Parece ficção científica — as lentes ativadas por impulsos elétricos requer...

Como Thammy vai ser pai? Saiba como é a técnica que permitiu gravidez de Andressa
De três a cinco dias após a fertilização dos óvulos, os embriões são implan...

Jovens defendem a ciência, mas desconhecem produção científica do País
Pesquisa inédita com mais de 2 mil pessoas revela o que os jovens pensam, s...

4 estratégias da ciência para ensinar seu corpo a acordar mais cedo
Estudo feito com pessoas notívagas descobriu como fazê-las dormir e acordar...

Efeito analgésico da bromelina do abacaxi é desvendado
Velha conhecida da indústria farmacêutica, a bromelina - enzima encontrada ...
“Superbactérias” resistentes poderão matar até 10 milhões em 2050
Instituto Lula divulgou que a causa da morte do neto do ex-presidente foi a...

Teoria científica explica por que o tempo “voa” quando envelhecemos
Com o passar dos anos, o corpo nos permite vivenciar menos do mundo, segund...

Descoberta genética abre portas para repelente contra Aedes aegypti
Cientistas descobriram gene que faz com que mosquito detecte ácidos do chei...

Paleontólogos encontram fóssil do maior dinossauro carnívoro da história
Animal viveu há mais de 66 milhões de anos e foi encontrado no Canadá...

Idade paterna avançada pode afetar a saúde do bebê, diz estudo
Uma pesquisa indica que, no geral, a paternidade tardia pode ser associada ...

Estes são os benefícios e riscos da edição genética
A edição de genes não precisa ser vista como um bicho de sete cabeças, mas ...

Astrônomos encontram evidências de planeta 13 vezes maior que Júpiter
Pesquisadores brasileiros encontraram evidências de um exoplaneta na conste...

Elevação do nível do mar exigirá obras de até R$ 1,5 bi em SP, diz estudo
Pesquisas mostram que, para conter o avanço do nível do mar no litoral bras...

Físico brasileiro Marcelo Gleiser recebe Prêmio Templeton de U$1,4 milhão
Entre os vencedores do prêmio, criado em 1972 estão Dalai Lama e Madre Tere...
Nós usamos cookies e outras tecnologias semelhantes para melhorar a sua experiência em nossos serviços, personalizar publicidade e recomendar conteúdo de seu interesse. Ao utilizar nossos serviços, você concorda com tal monitoramento. Informamos ainda que atualizamos nossa



